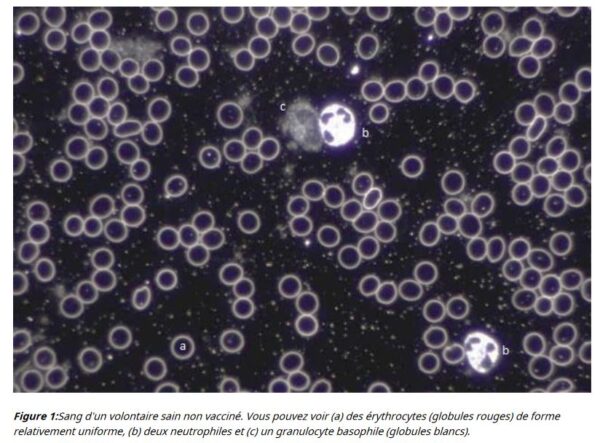

Un coup d’œil sur les vaccins Covid et le sang des vaccinés

Figure 4 : Ces 4 images illustrent la variété de phénomènes et d'objets inhabituels trouvés dans le sang de sujets vaccinés avec Comirnaty (BioNTech/Pfizer).
Photo: German Working Group for COVID Vaccine Analysis, GWG
Plus de 12,7 milliards de doses du vaccin Covid‑19 ont été administrées depuis que le traitement est devenu disponible il y a près de deux ans. Certains ont reçu une ou deux doses, tandis que d’autres en ont reçu davantage. Pourtant, beaucoup ne savent pas ce que contiennent réellement ces injections.
Le site Web de la Food and Drug Administration (FDA) fournit des listes d’ingrédients que les consommateurs intéressés peuvent consulter. Par exemple, les flacons de Moderna et de Pfizer/BioNTech sont connus pour contenir de l’acide ribonucléique messager (ARNm). La séquence génétique est conçue pour programmer les cellules afin qu’elles fabriquent la protéine spike, entraînant ainsi le système immunitaire à se prémunir contre la protéine spike caractéristique du virus Covid‑19.
Des ingrédients moins connus comprennent un mélange différent de lipides (graisses). Le vaccin de Pfizer, par exemple, contient du 4‑hydroxybutyl, et celui de Moderna du SM‑102. Ces injections contiennent également du polyéthylène glycol, du cholestérol, quelques sels (tels que le chlorure de potassium et le chlorure de sodium) et du sucrose (sucre).
Le vaccin de Johnson et Johnson (Janssen) ne contient pas d’ARNm mais présente comme principal mécanisme d’entraînement du système immunitaire un adénovirus recombinant, incompétent pour la réplication, exprimant la protéine spike du SRAS‑CoV‑2. Comme ses homologues à ARNm mentionnés ci‑dessus, le vaccin de J&J contient une variété d’autres produits chimiques, tels que l’acide citrique monohydraté, le citrate trisodique dihydraté, l’éthanol, la 2‑hydroxypropyl‑bêta‑cyclodextrine, le polysorbate‑80 et le chlorure de sodium.
Plusieurs éléments de la liste de ces ingrédients divulgués publiquement, comme l’ARNm et le SM‑102, suscitent la controverse. Les responsables de la santé publique, les organismes de réglementation et les fabricants de médicaments se sont empressés de défendre ces ingrédients en les considérant comme sûrs et nécessaires pour garantir l’efficacité des vaccins.
Les experts se sont également empressés de dissiper les craintes que les vaccins puissent contenir d’autres composants encore plus douteux, non divulgués au public.
Les Centres américains de contrôle et de prévention des maladies (CDC) abordent sur leur site Internet les préoccupations courantes liées aux vaccins, telles que celles‑ci, en déclarant que « les vaccins ne contiennent PAS d’ingrédients tels que des conservateurs, des tissus (tels que des cellules de fœtus avortés), des antibiotiques, des protéines alimentaires, des médicaments, du latex ou des métaux ».
En ce qui concerne les métaux, cependant, certaines recherches suggèrent le contraire.
Présence de métaux
Au début de l’année, le German Working Group for Covid Vaccine Analysis (GWG) a publié les résultats de l’examen de plusieurs flacons de vaccins. Le GWG est un réseau international composé de plus de 60 scientifiques, médecins et autres spécialistes. Leur objectif est de procéder à une analyse approfondie de ces vaccins en laboratoire.
Une microbiologiste et experte en gain de fonction du GWG, Sabine Stebel, a présenté les conclusions du groupe devant le World Council for Health General Assembly (WCHGA) le 5 septembre. Les chercheurs ont examiné la plupart des vaccins Covid 19 sur le marché : Johnson and Johnson, Moderna et AstraZeneca, ainsi que le seul vaccin qui a reçu l’approbation complète de la FDA – le Comirnaty de Pfizer (les autres options vaccinales ont simplement reçu une autorisation d’utilisation d’urgence).
Le GWG a examiné les flacons en utilisant la microscopie électronique à balayage (MEB) et la spectroscopie à rayons X à dispersion d’énergie. Ils ont trouvé des corps étrangers métalliques relativement grands. Les normes de l’Union européenne en matière de « Bonnes Pratiques de Fabrication » (BPF) autorisent des particules dont la taille ne dépasse pas un quart de micromètre, mais l’analyse de GWG a permis de découvrir de nombreuses particules métalliques provenant de plusieurs lots dont la taille était à une toute autre échelle, de l’ordre de nombres à deux chiffres. Ces objets métalliques ont été trouvés dans tous les flacons Pfizer et AstraZeneca étudiés, ainsi que dans certains flacons Johnson et Johnson, a indiqué GWG.
« Si on purifie une substance qui doit être injectée correctement, on ne devrait rien voir au microscope », a déclaré le Dr Stebel dans sa présentation. « Ces structures sont définitivement trop grosses pour être injectées dans une personne vivante. »
Les types de particules trouvées étaient constitués de métaux alcalins comme le césium et le potassium, de métaux alcalino‑terreux comme le calcium et le baryum, ainsi que de cobalt, de fer, de chrome et de titane. Les chercheurs ont également trouvé des terres rares comme le cérium et le gadolinium, ainsi que de l’aluminium, du silicium et du soufre.
Bien que certains de ces éléments ne soient pas toxiques et soient même essentiels à la santé humaine, beaucoup peuvent être très toxiques, même à faible dose.
C’est le cas du baryum, qui est toxique pour les humains et les animaux sous forme soluble. À des concentrations élevées, le baryum bloque les canaux potassiques dans la membrane cellulaire. Cela entraîne une perturbation du fonctionnement des cellules musculaires et une carence en potassium dans le sang, car le potassium reste dans les cellules en quantité accrue.
Un autre exemple de potentiel toxique présent dans les vaccins est le cobalt, un métal lourd. Bien que des quantités infimes de cobalt soient essentielles à la vie, en cas de surdose, il peut entraîner des symptômes tels que des nausées, des troubles visuels, des problèmes cardiaques et des lésions de la glande thyroïde.
Le gadolinium est un terre rare utilisé comme agent de contraste dans l’imagerie par résonance magnétique, mais ce métal peut être hautement toxique et s’accumuler dans le cerveau et les os.
Seuls les flacons Moderna ont révélé une concentration significative d’antimoine, plus importante que celle des autres éléments métalliques.
Changements dans le sang
En plus d’analyser les flacons de vaccins, les chercheurs du GWG ont analysé le sang des personnes vaccinées et l’ont comparé à des échantillons de sang de personnes non vaccinées. Ils ont constaté que le sang de tous les patients vaccinés testés (plus précisément ceux ayant reçu les vaccins Pfizer/BioNTech ou Moderna) présentait des « structures nouvelles », telles que des cristaux rectangulaires et des spirales.
« Ce type de structures n’a jamais été trouvé dans le sang humain auparavant. Ces structures ont été trouvées le plus souvent dans le vaccin Comirnaty de BioNTech/Pfizer », peut‑on lire dans le rapport.
Les personnes injectées ont systématiquement un sang altéré à 100%, comme on peut le constater avec la microscopie cellulaire à fond noir. Il s’agit notamment d’un flux sanguin entravé avec des globules rouges qui se collent les uns aux autres, jusqu’à la formation de rouleaux, et d’une stabilité et d’une survie des globules rouges profondément diminuées.
Une autre caractéristique des échantillons de sang vacciné était la dégradation du sang lui‑même. Le rapport fournit des images d’analyse de cellules sanguines vivantes montrant les membranes cellulaires d’érythrocytes (globules rouges ressemblant à des disques concaves) déformées et note une « désintégration inhabituellement rapide des différents types de cellules dans le sang vacciné ». De telles déformations cellulaires ne sont généralement observées que chez les malades chroniques et les personnes atteintes de maladies dégénératives graves.
Les chercheurs ont également observé des exemples fréquents de caillots sanguins et de modifications de la viscosité du sang, les individus vaccinés présentant une capacité de circulation sanguine réduite en raison de cellules sanguines collées les unes aux autres.

Figure 9 : Cette image du tissu du poumon d’une personne vaccinée révèle une particule biréfringente. Ce type de particules est considéré comme étranger au corps humain. On note la ressemblance frappante avec l’objet de la figure 8, en bas à gauche. (Avec l’aimable autorisation d’Arne Burkhardt et de ses collègues)
Contamination ou secret de fabrication ?
Ces métaux mystérieux ont‑ils une fonction quelconque dans la formule des vaccins ou sont‑ils simplement le résultat d’une contamination involontaire ?
Les fabricants de médicaments admettent que la contamination est possible, car le GWG n’a pas été le premier à détecter du métal dans les flacons. Le travail du groupe a été initialement inspiré par la découverte de contaminants en acier inoxydable dans des flacons de vaccin Moderna au Japon en 2021.
Les décès de deux hommes âgés de 30‑40 ans sont survenus quelques jours après avoir reçu leur deuxième dose de Moderna provenant des lots contaminés. Cependant, le ministère japonais de la Santé a déclaré que les particules d’acier inoxydable ne posaient apparemment pas un risque supplémentaire pour la santé. Pour sa part, Moderna n’a jamais indiqué la présence de ces particules dans la recette du vaccin. Le ministère a donc déclaré que la contamination s’était probablement produite au cours de la production.
Plus tard la même année, des matières étrangères ont été découvertes dans des flacons Pfizer inutilisés sur des sites de vaccination dans trois villes japonaises. Les flacons (95 au total) appartenaient tous au même lot, mais les villes qui disposaient des flacons ne pouvaient pas en identifier le contenu. Elles ont demandé à Pfizer d’analyser la matière blanche flottante.
Lors d’une conférence de presse, la filiale japonaise de Pfizer a émis l’hypothèse que cette matière était probablement constituée d’ingrédients de vaccins qui n’avaient pas été entièrement dissous et qu’elle ne posait aucun problème de sécurité ou d’efficacité. La société a déclaré dans un communiqué qu’elle était au courant du rapport et qu’elle « menait une enquête approfondie ».
Que peut‑on trouver d’autre dans ces vaccins ? Cela dépend de l’analyse. Prenons les conclusions d’une étude menée en Espagne, qui a révélé la présence d’oxyde de graphène, un type de nanomatériau utilisé dans diverses applications biomédicales.
Pablo Campra, professeur de sciences chimiques et chercheur à l’Universidad de Almería, en Espagne, a trouvé des traces de nanoparticules de type graphène dans de nombreux flacons provenant de quatre fabricants de vaccins différents. Le graphène a été détecté à l’aide d’une technique de spectroscopie appelée micro‑Raman, qui utilise des photons laser pour faire vibrer les molécules. Le rapport du Pr Campra de novembre 2021 détaille sa technique et les résultats de ses recherches.
Le Pr Campra a utilisé la microspectroscopie Raman après avoir examiné au microscope optique divers objets sélectionnés pour leur aspect graphénique et a trouvé des preuves concluantes de la présence de structures d’oxyde de graphène.
D’autres recherches ont détecté des nanostructures de graphène dans les vaccins Covid. Pourtant, l’industrie pharmaceutique et les experts en santé publique affirment explicitement que ces vaccins ne contiennent rien de tel.
Cependant, certains éléments laissent penser que les fabricants de vaccins pourraient un jour ajouter du graphène à leur formule. Une étude publiée en mai 2021 dans la revue Proceedings of the National Academy of Sciences a déterminé que les nanoparticules d’oxyde de graphène pourraient être efficaces dans un vaccin contre la grippe en raison des « capacités élevées de chargement d’antigènes et des propriétés immunologiques supérieures » de ce matériau. Les chercheurs affirment que ce matériau « peut être facilement adapté pour construire des vaccins muqueux [en spray] de différents agents pathogènes respiratoires ».
Une autre étude datant de mai 2021 suggère que les nanofeuillets d’oxyde de graphène (NFOG) pourraient constituer des ajouts précieux aux équipements de protection individuelle et à d’autres applications médicales.
Les chercheurs ont conclu que la seule préoccupation concernant l’ajout d’oxyde de graphène était son potentiel de toxicité.
Ce ne serait guère la première fois qu’une substance toxique serait ajoutée à un traitement. De nombreux médicaments utilisent des substances toxiques à faible dose pour obtenir un effet médicinal. L’antimoine, par exemple, le métal que le GWG a trouvé dans les flacons Moderna, est utilisé comme adjuvant antiprotozoaire dans certains vaccins traditionnels.
La question est de savoir si les métaux et les nanomatériaux que les chercheurs indépendants trouvent dans les flacons de vaccins font partie d’un secret de fabrication ou d’une contamination involontaire.
Le rapport du GWG indique que son équipe de recherche n’a trouvé aucun graphène dans les échantillons de vaccins qu’elle a analysés.
Cependant, les matériaux que le GWG a trouvés ne semblent pas non plus être un accident. Le rapport note que les doses Pfizer en particulier présentent un grand nombre de plaquettes et de formes cristallines qui peuvent « difficilement être interprétées comme des impuretés ».
« Elles apparaissent régulièrement et en grand nombre dans tous les échantillons », peut‑on lire.
Leur rapport souligne que ce rapport ne sera en aucun cas le dernier. Il s’agit davantage « d’une présentation préliminaire et en constante évolution de la recherche ». Les scientifiques appellent à poursuivre les travaux et les discussions.
« Il reste encore beaucoup à analyser, mais ce que nous avons trouvé – nous en sommes convaincus – est si important que le public en général et la communauté scientifique en particulier doivent en être informés. Il faut une compréhension plus large des dangers que les vaccins Covid‑19 font peser sur la santé et des recherches sur la façon dont les pires effets de ces vaccins peuvent être évités, ou du moins atténués », écrivent les chercheurs.

Conan Milner est un journaliste santé pour Epoch Times. Il a obtenu un diplôme dans les beaux-arts à la Wayne State University.
Articles actuels de l’auteur
25 novembre 2025
Neuf légumes-racines méconnus qui peuvent booster votre santé
25 mars 2024
Comment vraiment perdre du poids









